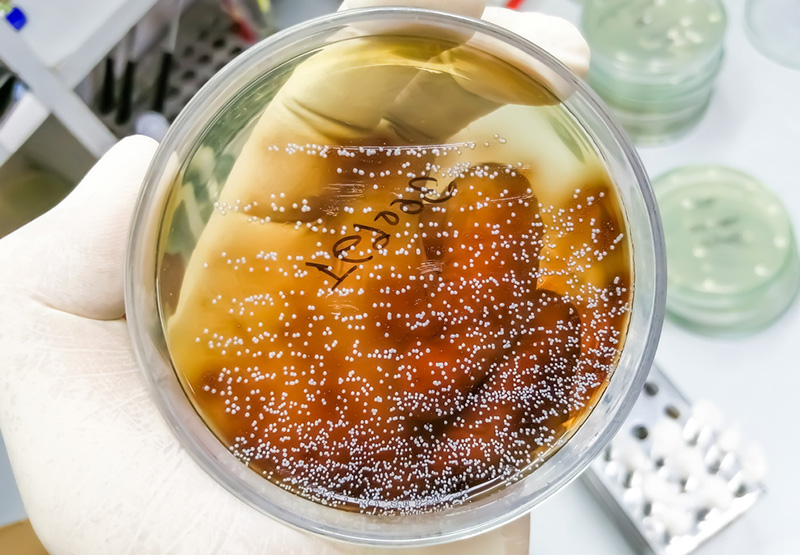
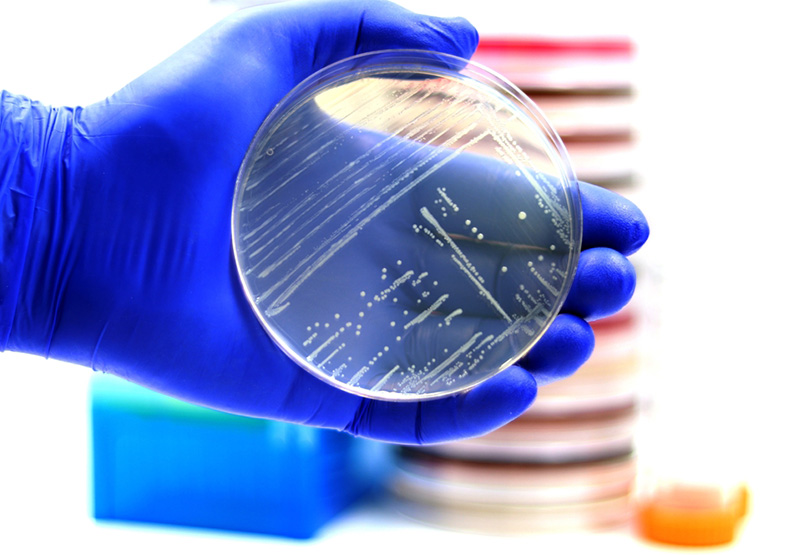

Tiêu Chí Lựa Chọn Tủ Ấm Vi Sinh Từ A-Z Cho Phòng Thí Nghiệm Đạt Chuẩn
Tủ ấm vi sinh là một thiết bị thiết yếu trong bất kỳ phòng thí nghiệm vi sinh nào, từ nghiên cứu cơ bản, kiểm nghiệm dược phẩm, thực phẩm đến chẩn đoán y tế. Việc lựa chọn một chiếc tủ ấm phù hợp không chỉ đảm bảo điều kiện tối ưu cho sự phát triển của vi sinh vật mà còn ảnh hưởng trực tiếp đến độ chính xác và độ tin cậy của kết quả. Bài viết này sẽ cung cấp một hướng dẫn toàn diện, tiêu chí lựa chọn tủ ấm vi sinh đạt chuẩn.
Tầm quan trọng của việc lựa chọn tủ ấm vi sinh phù hợp

Vi sinh vật, dù là vi khuẩn, nấm men hay nấm mốc, đều có những yêu cầu khắt khe về môi trường sống, đặc biệt là nhiệt độ.
Một sai lệch nhỏ trong việc duy trì nhiệt độ có thể dẫn đến ức chế sự phát triển, thay đổi đặc điểm sinh lý, hoặc thậm chí làm chết vi sinh vật, khiến kết quả nuôi cấy không còn ý nghĩa.
Do đó, đầu tư vào một tủ ấm vi sinh chất lượng, phù hợp với đối tượng nghiên cứu là bước đầu tiên đảm bảo thành công.
Các yếu tố then chốt khi lựa chọn tủ ấm vi sinh
Loại mẫu và loại vi sinh vật – Yếu tố quyết định khi lựa chọn tủ ấm vi sinh (Tích hợp Tiêu chuẩn)
Vi khuẩn thông thường (Mesophiles)

- Ví dụ: E. coli, Salmonella, Staphylococcus, Lactobacillus.
- Nhiệt độ tối ưu: Hầu hết phát triển tốt ở 30°C – 37°C.
- Tiêu chuẩn liên quan: Nhiều tiêu chuẩn quốc tế như ISO 6579-1 (phát hiện Salmonella spp.) hay TCVN 10780-1 tương ứng thường quy định ủ ở 37°C ± 1°C. Các tiêu chuẩn kiểm nghiệm thực phẩm khác quy định ủ đếm tổng số vi khuẩn hiếu khí ở 30°C ± 1°C (ví dụ ISO 4833-1 hoặc TCVN 4884-1:2015 (ISO 4833-1:2013)).
- Yêu cầu tủ: Tủ ấm tiêu chuẩn với dải nhiệt độ từ nhiệt độ môi trường +5°C đến 65°C hoặc 80°C là phù hợp. Đối lưu không khí tự nhiên hoặc cưỡng bức đều có thể sử dụng.
Vi khuẩn ưa nhiệt (Thermophiles)
- Ví dụ: Bacillus stearothermophilus (Geobacillus stearothermophilus), Thermus aquaticus.
- Nhiệt độ tối ưu: 45°C – 80°C.
- Tiêu chuẩn liên quan: Trong kiểm tra đồ hộp thực phẩm theo một số quy trình (ví dụ TCVN 4412:1987 về Đồ hộp thịt – Phương pháp xác định vi sinh vật, hoặc các hướng dẫn của FDA), việc ủ mẫu ở 55°C ± 2°C để phát hiện vi khuẩn ưa nhiệt gây hỏng đồ hộp là phổ biến.
- Yêu cầu tủ: Cần tủ ấm có khả năng gia nhiệt cao và duy trì nhiệt độ ổn định ở mức cao.
Tham khảo dòng tủ ấm vi sinh phù hợp trong nuôi cấy vi khuẩn thông thường và vi khuẩn ưa nhiệt Jeiotech IB4-05S

Nấm men và nấm mốc
- Ví dụ: Saccharomyces cerevisiae, Candida albicans, Aspergillus niger.
- Nhiệt độ tối ưu: Thường từ 25°C – 30°C.
- Tiêu chuẩn liên quan: Các tiêu chuẩn như ISO 21527-1 (đếm nấm men, nấm mốc trong thực phẩm có hoạt độ nước > 0.95) hoặc TCVN 8275-1:2010 (ISO 21527-1:2008) thường khuyến nghị nhiệt độ ủ khoảng 25°C ± 1°C trong 3 đến 5 ngày.
- Yêu cầu tủ: Cần chú ý đến độ ẩm. Một số tủ có khả năng kiểm soát độ ẩm hoặc có thể đặt khay nước bên trong.
Vi khuẩn ưa lạnh (Psychrotrophs/Psychrophiles)
- Ví dụ: Listeria monocytogenes (ưa lạnh tương đối, psychrotroph), Pseudomonas fluorescens.
- Nhiệt độ tối ưu: Psychrotrophs có thể phát triển ở 0-7°C nhưng nhiệt độ tối ưu thường 20-30°C. True psychrophiles có nhiệt độ tối ưu ≤15°C.
- Tiêu chuẩn liên quan: TCVN 7700-1:2007 (ISO 11290-1:1996) về phát hiện Listeria monocytogenes quy định các bước tiền tăng sinh và tăng sinh chọn lọc ở nhiệt độ như 30°C hoặc 37°C. Tuy nhiên, để đánh giá sự phát triển của vi sinh vật ưa lạnh nói chung trong thực phẩm bảo quản lạnh, việc ủ mẫu ở 7°C ± 1°C (theo ISO 17410 cho tổng số vi sinh vật ưa lạnh) hoặc các nhiệt độ tương tự là cần thiết.
- Yêu cầu tủ: Cần tủ ấm có khả năng làm lạnh (tủ ấm lạnh – refrigerated incubator).
Tham khảo dòng tủ ấm vi sinh phù hợp trong nuôi cấy nấm, mốc và vi khuẩn ưa lạnh Jeiotech Model IL3-15

Vi khuẩn kỵ khí (Anaerobes) và vi hiếu khí (Microaerophilic)
- Ví dụ: Clostridium spp., Bacteroides spp. (kỵ khí); Campylobacter spp. (vi hiếu khí).
- Nhiệt độ tối ưu: Thường là 35°C – 37°C.
- Yêu cầu khác: Kỵ khí – Môi trường không có oxy.
- Tiêu chuẩn liên quan: ISO 15213 (đếm Clostridium perfringens) hay TCVN 6191-3:1996 quy định ủ trong điều kiện kỵ khí.
- Thiết bị: Bình kỵ khí (Anaerobic jar) đặt trong tủ ấm tiêu chuẩn; tủ ấm CO₂/Tủ ấm đa khí (cho phép kiểm soát nồng độ O₂ và CO₂); buồng thao tác kỵ khí.
- Vi hiếu khí/Capnophilic (ưa CO₂):
- Tiêu chuẩn liên quan: Các quy trình nuôi cấy Campylobacter jejuni (ví dụ ISO 10272-1 hoặc TCVN 7925-1:2008) yêu cầu môi trường vi hiếu khí (khoảng 5% O₂, 10% CO₂, 85% N₂). Neisseria gonorrhoeae (theo hướng dẫn của CDC hoặc WHO) thường yêu cầu môi trường CO₂ 5%.
- Thiết bị: Tủ ấm CO₂ cho phép kiểm soát chính xác nồng độ CO₂ và thường cả độ ẩm.
Mẫu tế bào (Cell culture)
- Nhiệt độ tối ưu: Thường là 37°C cho tế bào động vật có vú.
- Yêu cầu khác: Rất nhạy cảm. Cần tủ ấm CO₂ với khả năng kiểm soát chính xác nhiệt độ, độ ẩm (thường >90% RH) và nồng độ CO₂ (thường 5%).
- Hướng dẫn/Tiêu chuẩn: Mặc dù không phải là tiêu chuẩn bắt buộc cho mọi phòng lab, các hướng dẫn thực hành tốt nuôi cấy tế bào (Good Cell Culture Practice – GCCP) thường nhấn mạnh các điều kiện này. Một số tiêu chuẩn ISO liên quan đến thử nghiệm độc tính tế bào in vitro (ví dụ dòng ISO 10993-5 về thử nghiệm độc tính tế bào của vật liệu y tế) cũng yêu cầu điều kiện nuôi cấy được kiểm soát chặt chẽ và ghi nhận.
Tham khảo dòng tủ ấm vi sinh phù hợp trong nuôi cấy vi khuẩn kỵ khí, hiếu khí và mẫu tế bào Jeiotech IB4-10S

Thông số kỹ thuật của tủ ấm (Tích hợp Tiêu chuẩn)
Dải nhiệt độ và độ chính xác/đồng đều/ổn định nhiệt độ
- Đảm bảo dải nhiệt độ của tủ bao trùm nhiệt độ nuôi cấy mong muốn.
- Độ chính xác, đồng đều, ổn định: Các yếu tố này rất quan trọng để đảm bảo rằng nhiệt độ thực tế trong buồng tủ là nhiệt độ quy định trong các tiêu chuẩn phương pháp thử (như các ISO, TCVN đã đề cập ở phần 2a).
- Tiêu chuẩn tham khảo: Các nhà sản xuất uy tín thường công bố các thông số này theo các chuẩn như DIN 12880:2007-05 (Tiêu chuẩn Đức quy định các thử nghiệm hiệu suất cho tủ ấm và tủ sấy). Ví dụ, DIN 12880 có thể yêu cầu độ đồng đều nhiệt độ không gian không vượt quá ±1°C và độ ổn định nhiệt độ theo thời gian không quá ±0.2°C tại 37°C (tùy thuộc vào kích thước và loại tủ).
Đối lưu không khí
- Đối lưu tự nhiên: Phù hợp cho mẫu nhạy cảm bay hơi.

- Đối lưu cưỡng bức (có quạt): Đảm bảo đồng đều nhiệt và phục hồi nhiệt nhanh. Quan trọng khi yêu cầu độ đồng đều nhiệt độ cao theo các phương pháp chuẩn.

Tham khảo thêm bài viết Phân biệt Tủ ấm đối lưu tự nhiên và tủ ấm đối lưu cưỡng bức của Thiết bị Hiệp Phát
Kích thước và dung tích
Lựa chọn dựa trên nhu cầu sử dụng.
Vật liệu cấu tạo
Buồng trong bằng thép không gỉ (inox 304 hoặc 316) là ưu tiên.
Khả năng kiểm soát độ ẩm
Cần thiết cho mẫu nhạy cảm mất nước, đặc biệt quan trọng trong tủ ấm CO₂ cho nuôi cấy tế bào (thường yêu cầu >90% RH để tránh làm tăng nồng độ môi trường nuôi cấy).
Khả năng kiểm soát CO₂/O₂
Đảm bảo cảm biến CO₂ (thường là IR – hồng ngoại) có độ chính xác và ổn định cao, đáp ứng yêu cầu của các phương pháp nuôi cấy tế bào hoặc vi khuẩn đặc biệt.
Lựa chọn cửa tủ ấm vi sinh
Cửa kính bên trong giúp quan sát mẫu. Gioăng cửa phải kín.
An toàn và cảnh báo
Cảnh báo quá nhiệt, lỗi cảm biến:
- Tiêu chuẩn an toàn: Các tủ ấm nên tuân thủ các tiêu chuẩn an toàn điện như IEC 61010-1 (Yêu cầu chung về an toàn cho thiết bị điện dùng trong đo lường, điều khiển và phòng thí nghiệm) và IEC 61010-2-010 (Yêu cầu cụ thể cho thiết bị gia nhiệt vật liệu trong phòng thí nghiệm).
- Tại Việt Nam, các TCVN tương ứng (ví dụ TCVN 7909-1 và TCVN 7909-2-010) được áp dụng.
Ghi dữ liệu và kết nối:
Khả năng ghi lại lịch sử nhiệt độ:
- Tuân thủ: Quan trọng cho việc tuân thủ GLP (Thực hành phòng thí nghiệm tốt), GMP (Thực hành sản xuất tốt) và các yêu cầu của ISO/IEC 17025 (Yêu cầu chung về năng lực của phòng thử nghiệm và hiệu chuẩn), nơi việc theo dõi và lưu trữ dữ liệu thiết bị là bắt buộc.
Lưu ý về Hệ thống Quản lý Chất lượng và Năng lực Phòng thí nghiệm
Ngoài các tiêu chuẩn kỹ thuật cho sản phẩm và phương pháp thử, cần lưu ý:
- ISO 9001: Áp dụng cho nhà sản xuất tủ ấm, đảm bảo sản phẩm được làm ra từ hệ thống quản lý chất lượng được công nhận.
- ISO/IEC 17025: Áp dụng cho phòng thí nghiệm sử dụng tủ ấm, đảm bảo năng lực kỹ thuật và hệ thống quản lý chất lượng của phòng thí nghiệm, bao gồm việc lựa chọn, sử dụng, hiệu chuẩn và bảo trì thiết bị đúng cách.
- GMP/GLP: Nếu tủ ấm được sử dụng trong môi trường tuân thủ GMP (ví dụ sản xuất dược phẩm) hoặc GLP (nghiên cứu tiền lâm sàng), việc thẩm định thiết bị (IQ – Installation Qualification, OQ – Operational Qualification, PQ – Performance Qualification) là bắt buộc.
Các lưu ý bổ sung
- Ngân sách: Cân đối giữa chi phí và yêu cầu kỹ thuật.
- Nhà cung cấp và dịch vụ hậu mãi: Chọn nhà cung cấp uy tín, có dịch vụ hỗ trợ tốt.
- Không gian lắp đặt và nguồn điện: Đảm bảo phù hợp.
Giải pháp Tủ ấm vi sinh đạt chuẩn từ Thiết bị Hiệp Phát

Dòng Tủ ấm vi sinh Jeiotech IB4 được phân thành hai loại dựa trên phương pháp truyền nhiệt (không khí): đối lưu tự nhiên và đối lưu cưỡng bức.
Để so sánh chi tiết và các tính năng của từng model dựa trên phương pháp truyền nhiệt, vui lòng tham khảo bảng dưới đây:
| Loại | Tủ ấm đối lưu cưỡng bức
IB4-V/ IB4-S |
Tủ ấm đối lưu tự nhiên
IB4-AV/ IB4-AS |
||
| Bộ điều khiển | Model IB4-V
(Nâng cao) |
Model IB4-S
(Tiêu chuẩn) |
Model IB4-AV
(Nâng cao) |
Model IB4-AS
(Tiêu chuẩn) |
| 5 inch | 3,5 inch | 5 inch | 3,5 inch | |
| Phương pháp truyền nhiệt (không khí) | Đối lưu cưỡng bức
Không khí nóng được luân chuyển cưỡng bức bằng động cơ quạt |
Đối lưu tự nhiên (Áo khí)
Không khí bên ngoài được làm nóng và truyền vào bên trong để lưu thông |
||
| Hình ảnh luân chuyển không khí |  |
 |
||
| Tính năng chính | Luân chuyển không khí nhanh và đều cho độ đồng đều nhiệt độ tuyệt vời | Cấu trúc Áo khí giảm thiểu sự bay hơi của môi trường nuôi cấy | ||
| Cách sử dụng | Khuyến nghị khi mở cửa thường xuyên hoặc nuôi cấy nhiều mẫu vì nó có thời gian phục hồi và biến đổi tốt hơn so với phương pháp đối lưu tự nhiên | Khuyến nghị cho các mẫu nhạy cảm với nhiệt độ hoặc các trường hợp cần giảm thiểu sự bay hơi của môi trường nuôi cấy khi nhiệt độ tăng chậm so với phương pháp đối lưu cưỡng bức | ||
Lựa chọn tủ ấm vi sinh là một quyết định quan trọng, ảnh hưởng lớn đến hiệu quả công việc và độ tin cậy của kết quả. Bằng cách xem xét kỹ lưỡng loại mẫu, loại vi sinh vật, các thông số kỹ thuật cần thiết, đồng thời tham chiếu các tiêu chuẩn, hướng dẫn liên quan trực tiếp đến ứng dụng và thiết bị, các phòng thí nghiệm có thể đầu tư vào một thiết bị phù hợp, bền bỉ và đáp ứng tốt nhất nhu cầu chuyên môn. Việc hiệu chuẩn và bảo trì định kỳ sau đó sẽ đảm bảo tủ ấm luôn hoạt động ở trạng thái tối ưu, phù hợp với các yêu cầu của tiêu chuẩn áp dụng.
Công ty TNHH Thiết bị Hiệp Phát hiện đang là đại lý ủy quyền cung cấp các dòng tủ ấm vi sinh hãng Jeiotech – Hàn Quốc. Nếu quý khách hàng đang có nhu cầu tìm mua các dòng tủ ấm vi sinh Jeiotech, đừng ngần ngại liên hệ với chúng tôi qua Sđt: 0919.537.653 – Mr. Tú hoặc Email: sales5@thietbihiepphat.com để được hỗ trợ kịp thời.

Để lại thắc mắc, chúng tôi sẽ giải đáp ngay cho bạn



 VN
VN














